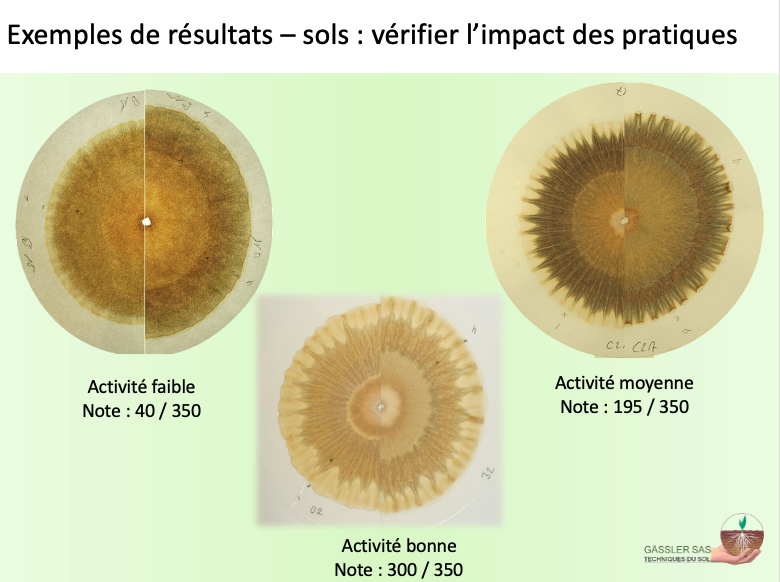

Fichier:Chromatographie Exemple sols1.png
Chromatographie_Exemple_sols1.png (780 × 582 pixels, taille du fichier : 411 kio, type MIME : image/png)
Description
| Description
|
|
|---|---|
| Source |
Envoyés directement par l'auteur |
| Date |
2025-05-14 |
| Auteur |
inconnu |
| Licence |
|
Conditions d’utilisation
Historique du fichier
Cliquer sur une date et heure pour voir le fichier tel qu'il était à ce moment-là.
| Date et heure | Vignette | Dimensions | Utilisateur | Commentaire | |
|---|---|---|---|---|---|
| actuel | 14 mai 2025 à 09:27 |  | 780 × 582 (411 kio) | Astrid Robette (discussion | contributions) | Œuvre de Marie-Thérèse Gassler venant de Envoyés directement par l'auteur téléversée avec UploadWizard |
Vous ne pouvez pas remplacer ce fichier.
Utilisation du fichier
La page suivante utilise ce fichier :